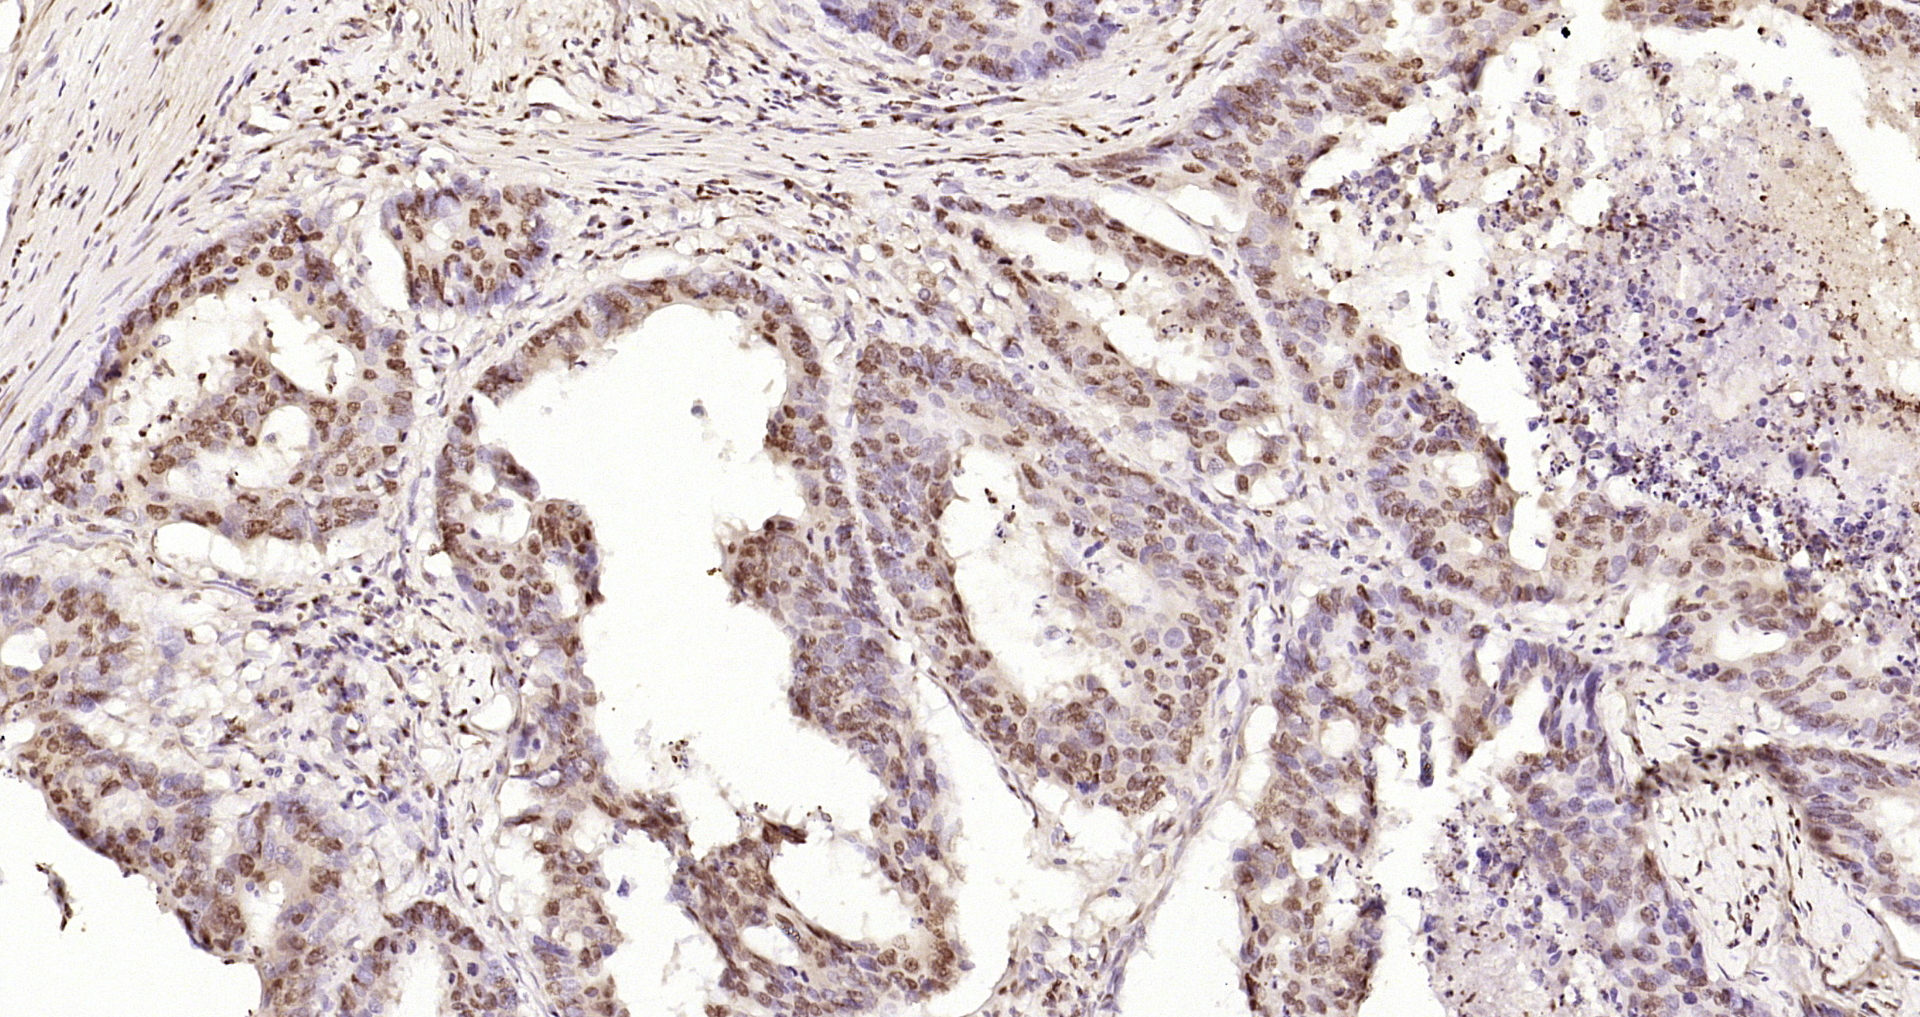

Paraformaldehyde-fixed, paraffin embedded rat brain; Antigen retrieval by boiling in sodium citrate buffer (pH6) for 15min; Block endogenous peroxidase by 3% hydrogen peroxide for 30 minutes; Blocking buffer (normal goat serum) at 37°C for 20min; Antibody incubation with CIDEC Polyclonal Antibody (bs-6796R) at 1:400 overnight at 4°C, followed by a conjugated secondary and DAB staining.
CIDEC Polyclonal Antibody
BS-6796R
ApplicationsImmunoFluorescence, Western Blot, ELISA, ImmunoCytoChemistry, ImmunoHistoChemistry, ImmunoHistoChemistry Frozen, ImmunoHistoChemistry Paraffin
Product group Antibodies
ReactivityHuman, Mouse, Porcine, Rat
TargetCIDEC
Overview
- SupplierBioss
- Product NameCIDEC Polyclonal Antibody
- Delivery Days Customer16
- ApplicationsImmunoFluorescence, Western Blot, ELISA, ImmunoCytoChemistry, ImmunoHistoChemistry, ImmunoHistoChemistry Frozen, ImmunoHistoChemistry Paraffin
- Applications SupplierWB(1:300-5000), ELISA(1:500-1000), IHC-P(1:200-400), IHC-F(1:100-500), IF(IHC-P)(1:50-200), IF(IHC-F)(1:50-200), IF(ICC)(1:50-200)
- CertificationResearch Use Only
- ClonalityPolyclonal
- Concentration1 ug/ul
- ConjugateUnconjugated
- Gene ID63924
- Target nameCIDEC
- Target descriptioncell death inducing DFFA like effector c
- Target synonymsCIDE-3, CIDE3, FPLD5, FSP27, lipid transferase CIDEC, cell death activator CIDE-3, fat specific protein 27
- HostRabbit
- IsotypeIgG
- Protein IDQ96AQ7
- Protein NameLipid transferase CIDEC
- ReactivityHuman, Mouse, Porcine, Rat
- Storage Instruction-20°C
- UNSPSC12352203

![Various whole cell extracts (30 μg) were separated by 12% SDS-PAGE, and the membrane was blotted with CIDEC antibody [N1C3] (GTX111008) diluted at 1:1000. The HRP-conjugated anti-rabbit IgG antibody (GTX213110-01) was used to detect the primary antibody.](https://www.genetex.com/upload/website/prouct_img/normal/GTX111008/GTX111008_40247_20221028_WB_22110201_787.webp)